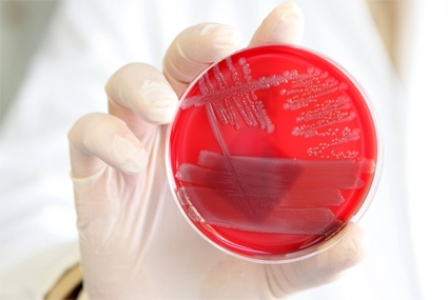

Sesamzaad is een hoofdpijndossier voor de EU (update)
In de maanden september, oktober en november 2020 was er een niet aflatende stroom recalls als gevolg van verontreiniging van het sesamzaad met ethyleenoxide.

In de maanden september, oktober en november 2020 was er een niet aflatende stroom recalls als gevolg van verontreiniging van het sesamzaad met ethyleenoxide.

Het Centraal Bureau Levensmiddelenhandel (CBL) is blij met het rapport over voedselintegriteit van Europarlementariër Esther de Lange. De retailorganisatieis positief over de aandacht die het Europees Parlement (EP) besteedt aan voedselvertrouwen dankzij dit rapport.

In Groningen, Drenthe en Rotterdam start een grootschalige studie naar de EHEC-bacterie die een jaar zal duren. Het Universitair Medisch Centrum Groningen coördineert het onderzoek.

Inspecteurs van de Nederlandse Voedsel en Waren Autoriteit (NVWA) voeren controles uit bij een uitsnijderij in Enschede. De reden van de inspectie: de EHEC-bacterie.

De recall van de zalm van Foppen en vorig jaar de kiemgroenten die de EHEC-crisis veroorzaakten; het ligt nog vers in het geheugen. Wat is er te leren van deze en andere recalls waarmee elk bedrijf te maken kan krijgen?

HET Instrument focust deze editie met een Voeding X-pedition en het seminar LabAnalyse op de voedingsmiddelenindustrie. De vakbeurs wordt van 25 tot en met 28 september gehouden in RAI, Amsterdam.

Supermarkten kopen nog steeds nauwelijks groente en fruit in bij lokale tuinders. De Nederlandse groente- en fruittelers hebben te maken met lage marges.

Eurocommissaris John Dalli prijst de Europese voedselveiligheidsstandaarden als de hoogste in de wereld. Toch steeg het aantal meldingen van producten die niet voldeden aan EU-voedselveiligheidswetgeving met 6,7% en worstelde de Europese Commissie met de EHEC-crisis.
Nadat onlangs in Duitsland een zesjarig meisje stierf als gevolg van een besmetting met de EHEC-bacterie, doken weer twee nieuwe ziektegevallen op in de Noord-Duitse stad Hamburg.
Het begon in mei met een aantal ziektegevallen in Duitsland en eindigde in een ramp van Europese omvang. De uitbraak van de Escheria colibacterie van de stam O104:H4, kortweg EHEC kostte 52 levens, zorgde voor ruim 4.300 besmettingen en 852 mensen kampen nog steeds met nierproblemen. De EHECuitbraak beheerste dit jaar maandenlang het nieuws.